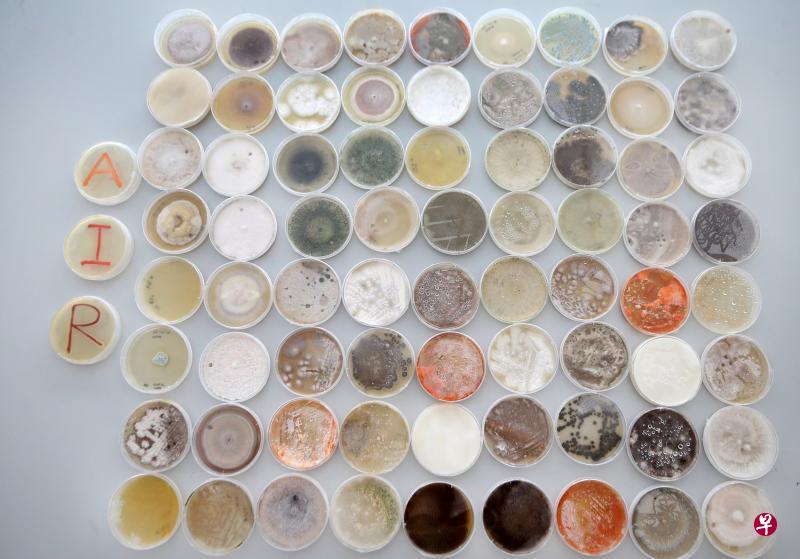
南洋理工大学新加坡环境生物中心研究员发现,新加坡的空气中存在至少1200种细菌与真菌。图为研究员从空气样本培养出的菌落。(严宣融摄) 南洋理工大学新加坡环境生物中心研究员发现,新加坡的空气中存在至少1200种细菌与真菌。图为研究员从空气样本培养出的菌落。(严宣融摄)

南洋理工大学新加坡环境生物中心的研究发现,新加坡的空气中有至少1200种细菌与真菌。人们每天平均吸入11立方米或1万1000公升的空气当中,白天可含有约5万个菌类微生物细胞,晚上的量更可达30倍至100倍。
最新研究发现,身处新加坡这样的热带地区,人们每天都从空气中吸入大量菌类微生物,而且天天开关冷气还会使室内空气更潮湿,更容易滋长真菌。
南洋理工大学新加坡环境生物中心昨天发表研究结果,发现新加坡的空气中,有至少1200种细菌(bacteria)与真菌(fungi)。
人们每天平均吸入11立方米或1万1000公升的空气。研究发现,这些被吸入的空气中,白天可含有约5万个菌类微生物细胞,晚上的量更可达到30倍至100倍。
领导这项研究的南大基因组学教授舒斯特(Stephan Schuster)在记者会上说,每当人们开冷气,室内空气迅速冷凝后附着在物体表面,增加了房间的湿度,再加上气温低,是真菌生长的最佳环境。
“我们的研究团队成员有时开玩笑说,不要太早进办公室,因为冷气刚开不久,空气中很多真菌。”
舒斯特说,要减少真菌滋长,最好是缓慢降温,唯有当室内长时间开着冷气,空气越来越干燥,真菌才会减少。
南大科学家是利用新颖的采样与脱氧核糖核酸(DNA)测序技术来发现新加坡的空气生态环境中有什么生物,还可按它们的基因组辨识“身份”。
由于这在技术上非常困难,因此之前的研究都无法详细辨认空气中的生物。
南大的超低生物量分析技术,可让研究员连少量空气中的每小时微生物变化都能探测得到,不用等到采集一周或一个月的生物量才进行分析,以此获取详细信息。
舒斯特说:“新加坡目前是世上拥有最详细空气微生物图谱的国家。”
由于可以按小时来分析,研究发现,白天的空中生物多数是细菌,晚上则是真菌。舒斯特说,这是因为晚上气温较低,湿度较高,真菌容易滋长。
他说,健康的人晚上吸入较多真菌对身体不会有什么影响,还是可以放心在户外活动。
团队将研究托儿所幼儿 会否与同伴“交换”菌类
至于有呼吸问题的人,研究团队正与南大李光前医学院合作,研究空中生物对支气管炎、慢性阻塞性肺病,以及严重哮喘病患有什么影响。
此外,团队也在展开其他应用研究,如抽取托儿所的空气样本,看幼儿是否在托儿所跟同伴“交换”菌类,并把这些微生物“带回家”。团队也与全国传染病中心合作,看医院访客与医疗人员是否交叉感染。